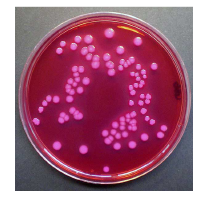

El mundo de cosmética y productos cosméticos es muy amplio y engloba una gran variedad de productos, ya sean para la higiene personal, el cuidado o el embellecimiento del cuerpo. Son productos que forman parte de nuestro día a día y, por ello, son imprescindibles. En los últimos años, el sector de la cosmética ha crecido y, por tanto, también han aumentado las fábricas dedicadas a la fabricación de productos cosméticos. Además, también se ha incrementado el uso de ingredientes naturales, ya que los usuarios cada vez revisamos más los componentes de los productos.
En el artículo de hoy, vamos a conocer los controles y análisis necesarios de productos cosméticos y análisis de superficies para conocer la cosmética y productos cosmética.
Control de calidad de cosmética y productos cosméticos
Al igual que otros productos, los cosméticos tienen que pasar un control de calidad tanto microbiológico como fisicoquímico. Estos controles de calidad se realizan para asegurar que el producto mantiene su objetivo, su textura y aspecto durante un largo periodo de tiempo, puesto que el calor, el frío, cambios bruscos de temperatura, la luz y contaminaciones microbiológicas pueden alterar el aspecto y su función.
Son productos cosméticos de aplicación directa (cremas, jabones, lociones…) que si tienen presencia de microorganismos patógenos y/o pH inadecuados podrían exponer nuestro cuerpo a cicatrices o enfermedades infecciosas.
Análisis microbiológicos cosméticos
En Innotec laboratorios se ejecutan análisis microbiológicos según la norma UNE-EN ISO 21148 y siguiendo la Farmacopea Europea. Entre los microorganismos que analizamos se encuentran los siguientes:
- Detección de Staphylococcus aureus.
- Detección de Pseudomona aeruginosa.
- Localización de Escherichia coli.
- Localización de Candida albicans.
- Recuento de Bacterias aerobias mesófilas.
- Recuento de Levaduras y mohos.
Entre los ensayos físico-químicos que tiene la cosmética, los métodos comunes son:
- Determinación de pH.
- Determinación de la densidad.
SABER MÁS SOBRE EL PROCEDIMIENTO DE MUESTREO SEGÚN EL TIPO DE ANÁLISIS
Control de calidad en productos cosméticos
A su vez, también se realizan ensayos para el control de calidad en jabones blandos según la norma UNE-EN ISO 1499, entre los que cabe destacar:
- Identidad.
- Pureza.
- Sustancias insolubles en etanol.
- Álcali libre.
- Pérdida por secado.
- Determinación del contenido.
Pero no solo se deben hacer controles del producto final, también desde el momento de su fabricación se debe asegurar que no existe contaminación porque está en juego la seguridad de todos. Desde Innotec Laboratorios somos conscientes de la importancia que tiene y se puede controlar la calidad microbiológica del ambiente:
- Recuento de Bacterias aerobias.
- Recuento de Levaduras y mohos.
Y también la calidad microbiológica de las superficies de trabajo:
- Recuento de Bacterias aerobias.
- Recuento de enterobacterias.
SABER MÁS SOBRE ANÁLISIS DE SUPERFICIES, SU IMPORTANCIA EN LA INDUSTRIA ALIMENTARIA
Gracias a estos exhaustivos análisis, nuestros clientes podrán implementar mejoras en la composición de los productos y asegurar el cumplimiento de las normas de calidad y seguridad, garantizando así la máxima calidad y generando confianza en los clientes. En caso de requerir nuestros servicios de análisis de cosmética en tu empresa, no dudes en ponerte en contacto con nosotros.







